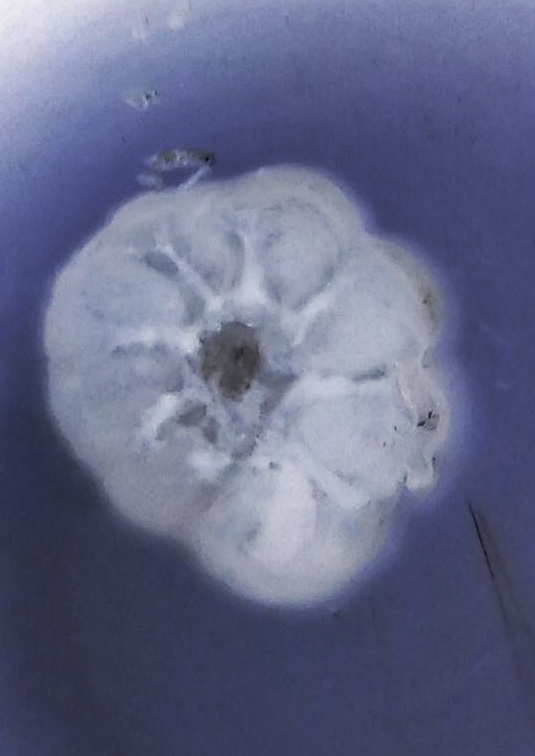
2018-12-5-20-40-38-01.jpeg

Activity

Microorganisms

Plants

Unknown

Information

Insects

Workshops

Lesson Plans

Fungi & Lichen

Animals

Non Living
Mediashowing 12 of 577

Photo posted on Jan 19, 2026
image

Photo posted on Jan 19, 2026
image

Photo posted on Jan 19, 2026
image
Photo posted on Jan 19, 2026
image

Photo posted on Jan 19, 2026
image

Photo posted on Jan 19, 2026
image

Photo posted on Jan 19, 2026
image

Photo posted on Jan 19, 2026
image

Photo posted on Jan 19, 2026
image
Video posted on Jan 19, 2026
video
Video posted on Jan 19, 2026
video

Photo posted on Jan 19, 2026
image
More Posts from Dr Rafikh Shaikhshowing 20 of 115
Similar Foldscopers
No biography available.
No post images available.
No biography available.
No post images available.
No biography available.
No post images available.
I am a undergrad interested in science and technology
No post images available.
No biography available.
No post images available.
We are a group of students, volunteers and staff working with TIFR Hyderabad's Science Education and Outreach program: http://www.tifrh.res.in/~outreach/
No post images available.
No biography available.
No post images available.
Human observer of life. https://sukshmadarshin.wordpress.com
No post images available.
@Conacyt_MX research fellow at @LaUASLP 🇲🇽 studying the 🧠
with #fNIRS. 🏀 & 🎮 enthusiast. #SoyCátedraCONACYT
No post images available.
No biography available.
No post images available.

 Joined Aug 29, 2017
Joined Aug 29, 2017 From Mumbai
From Mumbai
 0 Applause
0 Applause 0 Comments
0 Comments



























